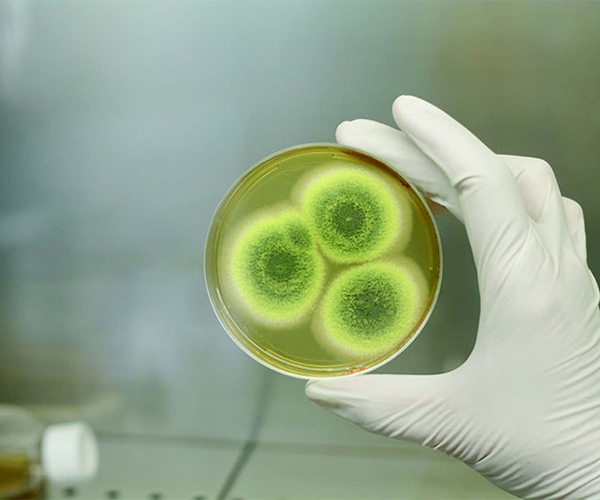

活疫苗生产用分离机
概述
活疫苗(如麻疹、腮腺炎、风疹、黄热病、水痘、结核病/卡介苗、斑疹伤寒及轮状病毒疫苗)的生产是一个精细且要求极高的过程,需要先进设备以达到安全、高效和纯度的高标准。华鼎分离机提供创新的离心解决方案,专为满足活疫苗生产的严格要求而设计。
离心机在活疫苗生产中的作用
 |
 |
|
细胞收获 华鼎离心机能高效地从生长培养基中回收活细胞或微生物,这是疫苗生产的关键步骤。其温和而有效的分离过程能极大限度减少对细胞的损伤,保持其活力和生物活性,这对活疫苗的效力至关重要。 |
纯化与澄清 收获后的纯化对于去除细胞碎片、蛋白质和其他不需要的副产物等杂质至关重要。华鼎离心机配备精密系统,可在不损害疫苗完整性的前提下实现这一目标,从而提升产品的质量与安全性。 |
 |
 |
|
满足不同规模的生产需求 无论是小规模研究批次还是大规模工业化生产,华鼎都能提供适应不同生产能力的离心解决方案。其高速、连续运行的离心机都可在不牺牲性能或产品质量的前提下,实现生产规模的无缝扩大。 |
对生物材料的温和处理 活疫苗通常涉及敏感的生物培养物。华鼎离心机设计有液压密封进料系统和温和的排料机制等特性,以极大限度减少剪切力,保护活细胞和病毒的脆弱特性。 |
|
|
|
无菌与生物安全保障 活疫苗生产要求严格的无菌条件以避免污染。华鼎离心机构建了以下保障: |
按疫苗类型的应用细分
|
病毒性疫苗(麻疹、腮腺炎、风疹、水痘、黄热病) 病毒性疫苗的生产需要对病毒培养物进行精确的分离与澄清,以维持活病毒颗粒的效力和有效性。华鼎的高速离心机专为此类生产设计,具备以下优势: |
 |
 |
细菌性疫苗(结核病卡介苗、斑疹伤寒疫苗) 细菌性疫苗的生产依赖于对细菌培养物的精心处理,以保持其活力和免疫原性。华鼎的卧螺离心机在此领域表现优良。 |
|
轮状病毒疫苗 对于轮状病毒等儿科疫苗而言,获得理想的得率与纯度至关重要。华鼎的碟式离心机提供高速分离技术。 |
 |
华鼎疫苗生产离心机的先进特性
|
1.蒸汽灭菌型号 华鼎离心机配备集成式蒸汽灭菌设计,无需拆卸即可简化清洁与灭菌流程。这确保了生产全程的无菌条件,对疫苗安全和法规符合性至关重要。通过消除人工清洁步骤,这些型号减少了停机时间,提高了生产效率,是严格要求无菌环境的理想选择。 |
2.全密闭进料系统 华鼎离心机的全密闭进料系统为处理敏感或有害生物材料提供完全封闭的环境。该设计在整个操作过程中保持无菌状态,在确保活疫苗完整性的同时,保护操作人员及周边环境。全密闭系统还能极大限度减少物料处理过程中的剪切力,保护脆弱细胞或病毒颗粒的活性。 |
|
3.自清洁技术 华鼎离心机配备先进的自清洁机构,可自动清除系统中的废物与污染物。此功能减少了人力需求,延长了维护周期,并支持连续运行。通过保持离心机长期清洁与可运行状态,自清洁技术显著提升了整体生产率,尤其适用于高通量生产线。 |
4.高分离精度 华鼎的多区分离系统在疫苗生产过程中实现了组分分层精度。这些系统能够精确去除杂质、细胞碎片及不需要的副产物,确保产品的高纯度与高效率。高速分离能力也优化了得率,减少了浪费,提升了成本效益。 |
为何选择华鼎作为活疫苗生产合作伙伴?
每一款疫苗的生产工艺都是独特的,华鼎深谙定制化解决方案的必要性。我们提供可根据特定生产需求进行设计的离心机,无论是用于小规模试点项目还是大规模工业化生产。定制选项包括处理能力调整、专用进料系统以及先进的控制功能,以适应多样化的应用场景。
华鼎分离机致力于通过引入先进的离心解决方案推动疫苗生产进步。凭借数十年的分离技术经验,华鼎为疫苗生产商提供的专业知识、可靠的设备与全方面的支持。无论您生产的是病毒性还是细菌性疫苗,华鼎离心机都能提供满足行业高标准所需的精度、可扩展性与安全保障。

 English
English русский
русский Español
Español عربى
عربى 中文简体
中文简体






























